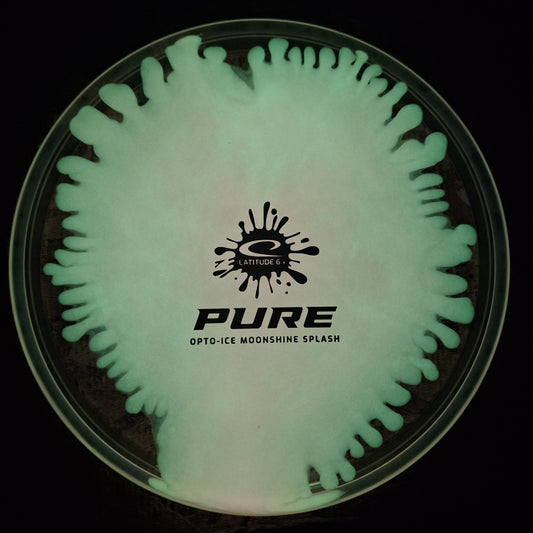
Latitude 64 Opto-Ice Moonshine Splash Pure

Collection: Glow Round!
-
Westside Discs VIP Moonshine Prince
Regular price $20.99 USDRegular priceUnit price / per -
Westside Discs VIP Moonshine Destiny
Regular price $20.99 USDRegular priceUnit price / per -
Westside Discs VIP Moonshine Sword
Regular price $20.99 USDRegular priceUnit price / per -
Discmania Glow Flex 3 P-Line P2X- Gannon Buhr Triumph Series 2025 World Champion
Regular price $15.99 USDRegular priceUnit price / per -
Discmania Eternal Void 2- Kyle Klein Signature Series Glow Horizon C-Line MD4
Regular price $25.99 USDRegular priceUnit price / per -
Dynamic Lucid Moonshine Verdict-Reaper of Pars
Regular price $20.99 USDRegular priceUnit price / per -
Axiom Particle Eclipse Hex Halloween Edition
Regular price $24.95 USDRegular priceUnit price / per$28.95 USDSale price $24.95 USDSale -
Axiom Particle Proton Insanity Halloween Edition
Regular price $20.95 USDRegular priceUnit price / per$23.95 USDSale price $20.95 USDSale -
Axiom Particle Eclipse Fireball Halloween Edition
Regular price $24.95 USDRegular priceUnit price / per$28.95 USDSale price $24.95 USDSale -
Discmania Glow Horizon C-Line DD2
Regular price $23.99 USDRegular priceUnit price / per -
Westside Discs VIP-Ice Orbit Moonshine Gatekeeper-Desolate Shield
Regular price $24.99 USDRegular priceUnit price / per -
Latitude 64 Opto Moonshine River
Regular price $20.99 USDRegular priceUnit price / per -
Latitude 64 Opto-Ice Moonshine Splash Pure
Regular price $24.99 USDRegular priceUnit price / per -
Prodigy FX-4 750 Color Glow Lunar Soul Stamp
Regular price $21.99 USDRegular priceUnit price / per -
Infinite Discs Joel Freeman Signature Metal Flake C-Blend Glow Chariot
Regular price $24.99 USDRegular priceUnit price / per -
Infinite Discs C-Blend Glow Khonsu
Regular price $19.99 USDRegular priceUnit price / per